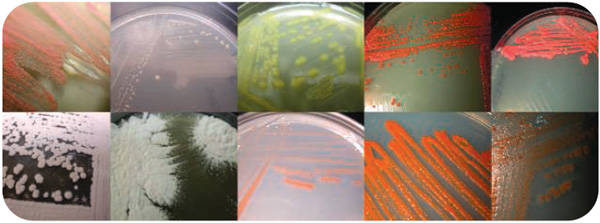
Выделенные из губок актинобактерии, которые удалось культивировать в лаборатории. Фото из статьи в Science

Исследования последних лет показали, что самые простые многоклеточные — губки — представляют собой сложный симбиотический комплекс, включающий более сотни различных микроорганизмов. Многие из этих симбионтов встречаются только в губках. Более того, состав симбионтов у губок разных видов и в разных частях света оказался очень схожим. Это означает, что губки приобрели симбионтов в самом начале своей эволюции и по неизвестной причине сохранили их состав неизменным.
В последние 10–15 лет биологи начали пересматривать твердо установленные постулаты и перекраивать свою биологическую аксиоматику. Среди главных причин такого революционного движения — развитие новых методов микроскопирования и молекулярной биологии, в частности возможность читать генетические последовательности. Даже самый, казалось бы, простой организм — губка — в беспощадном свете новых методов видится уже довольно сложным.
Губку можно схематично представить в виде двух слоев клеток — эпителиальных и пищеварительных, а между слоями формируется твердый скелет из разного рода спикул (известковых или кремнезёмных игл). Хорошо известны старые опыты, в которых губку размалывали в кашу, а затем наблюдали, как клетки сами собой сортируются и снова складываются в полноценное животное. По сей день тянется дискуссия, следует ли относить губок к высокоорганизованным колониальным одноклеточным или к низкоорганизованным многоклеточным. Что может быть проще губок?
Но в последние годы выяснилось, что каждая губка — это конгломерат, включающий в себя более сотни (!) симбиотических организмов. Это стало очевидным после того, как исследователи из Алабамского университета в Бирмингеме (США) определили состав нуклеотидных последовательностей 16S-РНК у губок. Прежде симбионтов определяли с помощью лабораторного культивирования всей клеточной массы. Таким способом можно выявить только 5% микроорганизмов-симбионтов, потому что большинство симбионтов (да и свободноживущих микроорганизмов) в лабораторных пробирках не растут. Группу культивируемых в лаборатории микроорганизмов-симбионтов составили в основном фотосинтетики — цианобактерии и одноклеточные водоросли. Как и у кораллов, у губок эти микроорганизмы фиксируют углекислоту, снабжая гетеротрофную губку пищей и одновременно кислородом и энергией. Помимо них культивируются еще и актинобактерии.
Но кто еще, помимо фотосинтетиков, оказался сожителем губок? По 16S-РНК опознали архебактерий, альфапротеобактерий, актинобактерий, бактерий-нитрификаторов. В общей сложности микромир губок оказался весьма разнообразным: около 100 видов, принадлежащих к 14 типам бактерий, 2 типам архебактерий и нескольким видам эукариот. Многие из этих микроорганизмов определены пока только внутри губок, а в воде вокруг их нет. Вполне возможно, что своих симбионтов губка-родитель передает по наследству потомству: в сперматозоидах и в личинках губок обнаружили симбиотических бактерий. Замечательно, что набор симбионтов разных видов губок из разных частей света оказался очень сходным. Это означает, во-первых, что губки приобрели своих симбионтов в самом начале эволюционного пути. Во-вторых, что жизнеспособность и функционирование такого организма, как губка, требует совершенно определенного набора условий, который обеспечивается специфическим набором симбионтов.
Получается, чтобы быть губкой, недостаточно иметь два слоя клеток и скелетные иглы, необходимо еще присутствие сотни действующих лиц. Какие из этих действующих лиц главные и обязательные, а какие второстепенные и необязательные — это ученым еще предстоит выяснить. Может ли вообще губка жить без своих симбионтов? Нужно понимать, что определить функции каждого из сожителей по отдельности практически невозможно — ведь их нельзя культивировать и, следовательно, выяснить, кто чем живет. Пока что удается лишь проследить с помощью радиоактивных меченых атомов путь отдельных веществ по цепочке микроорганизмов. Самих микроорганизмов «помечают» при этом разноцветными флуоресцентными белками. Так что можно видеть, что едят различные участники губкового консорциума.

Все эти исследования заставляют философски и методологически пересмотреть вопрос о сущности целостного организма. Даже такой просто устроенный организм, как губка, на самом деле оказался набором из множества различных организмов, каждый из которых предпочитает совместную жизнь единоличному обитанию. Другой вопрос: почему сами губки эволюционировали, а их сожители сохранили консервативный облик? Ведь у всех губок набор симбионтов более или менее единообразен. Всё это вопросы для нового поколения биологов.
Но исследователи убеждены, что их работа имеет не только академический интерес. Известно, что вытяжки губок обладают хорошим лечебным эффектом для многих заболеваний, в частности подавляют рост раковых клеток. Вполне возможно, что клиническое действие оказывают не сами губки, а их симбионты. Ведь очевидно, что одна из функций симбионтов — это защищать хозяина от нежелательных паразитов. В этом случае имеет смысл поискать среди бактерий тех, кто реально может справиться с паразитарными инфекциями. Так, вещество манзамин А (manzamine), выделенное из губок, гораздо действеннее в лечении малярии, чем все известные препараты. Ученым из Института биотехнологий Мэрилендского университета в Балтиморе (США) удалось показать, что это вещество синтезируется всеми видами губок, так что вероятность его бактериального происхождения чрезвычайно высока. Если ученые найдут эту гипотетическую бактерию, то наладить производство манзамина А при нынешних технологиях будет не очень сложно.
Источник: Gretchen Vogel. The Inner Lives of Sponges // Science. 23 May 2008. V. 320. P. 1028–1030 (DOI: 10.1126/science.320.5879.1028).
Елена Наймарк



